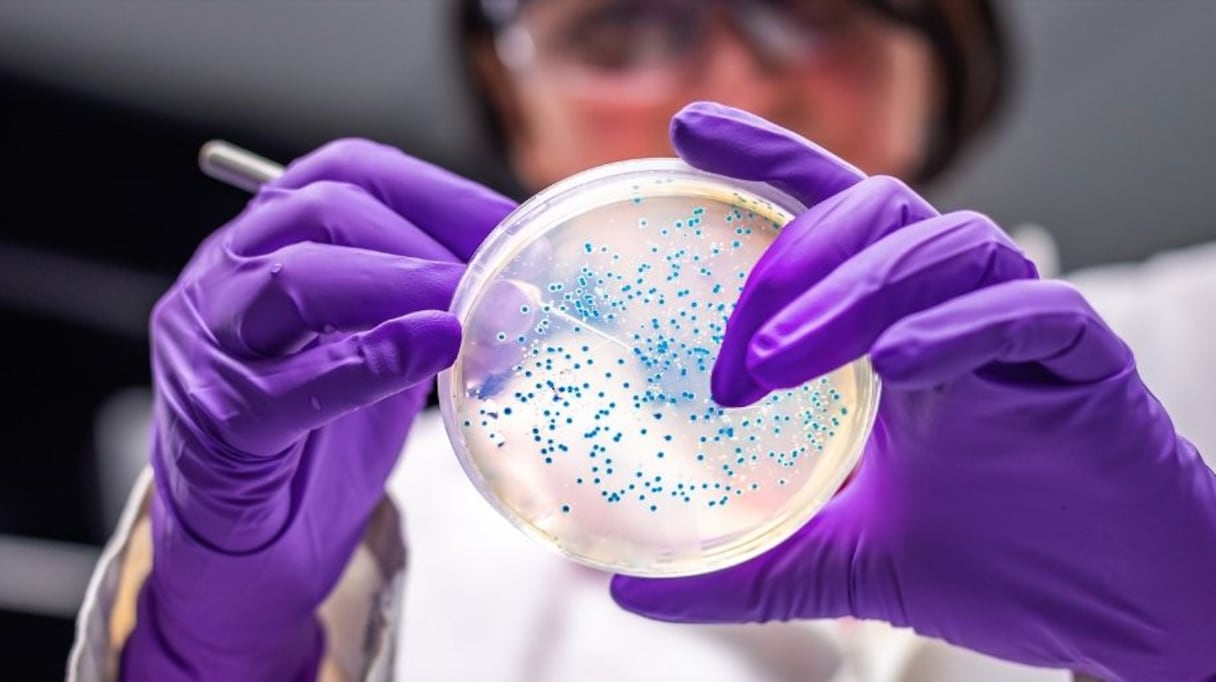
بكتيريا السالمونيلا

وقالت الشركة في بيان لها: "سلامة الأغذية أمر بالغ الأهمية بالنسبة لنا، وقد أبلغنا سلطات الغذاء البلجيكية بالحادث".
وأضافت: "ندرب موظفينا لضمان سلامة الأغذية، وقد سمح لنا ذلك بتحديد المخاطر بسرعة والبدء بنجاح في تحليل السبب الجذري".
وأكدت الشركة إنها اتخذت عدة إجراءات احترازية منها سحب جميع المنتجات المصنعة منذ وقت إجراء الاختبار، مضيفة: "سيظل الإنتاج معلقا حتى إشعار آخر".
وأكدت الشركة أنها ستبقى على تواصل مع سلطات الغذاء البلجيكية، وسيتم تنظيف الخطوط وتطهيرها قبل استئناف عملية الإنتاج.